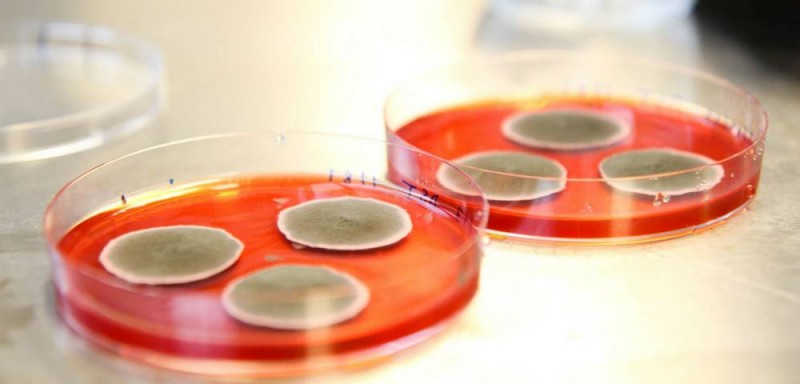

食品和饮料领域中最令人兴奋的创新往往来自于那些对整个行业知之甚少的小型初创企业。在日前刚刚结束的欧洲食品配料展览会(FiE)上,一些国际性的创新项目吸引了众多参会嘉宾的关注。从微藻健康食品、高蛋白冰淇淋,到健康的低GI工业糖、昆虫蛋白,到更天然的色素提取技术等等…这些颇具开拓性的产品和技术创新是怎样的?又将为食品饮料行业带来哪些新的改变?
▎1、微藻健康食品Alver Golden Chlorella
为解决行业内对风味低损耗、高蛋白食物的需求,这家新创瑞士公司利用GoldenChlorella微藻开发了一系列健康美味可持续的食物。
Golden Chlorella中的蛋白质含量为63% (肉类为25%),同时富含钾、镁、锌和维生素B。小球藻以其在增强免疫系统抗性及身体排毒(尤其是重金属)方面的特性而备受人们青睐,同时在保护大脑、眼部、皮肤健康以及降体重、降血压、降低胆固醇方面也有一定的功效。

因其温和的风味和独特的金色,Alver Golden Chlorella被声称是真正的与众不同的创新产品。它通过自然发酵过程生产,可以在不影响消费者饮食或烹饪习惯的前提下,很容易地添加到所有的食品中。这款独特的产品有效地将微藻从补充剂变成了一种易于使用的日常食品配料,而且能够改善身体健康和碳足迹。
Golden Chlorella采用发酵工艺最大地限度地减少了微量和宏量营养素的损耗。该产品具有高度的可持续性,平均需水量减少44倍,耕地占用减少41倍,二氧化碳排放量比牛肉蛋白少36倍。

Alver Golden Chlorella是由Mine Uran和商业战略家Majbritt Byskov-Bridges共同创立的,前者曾是雀巢蛋白质研发部门的负责人,过去20年中一直在寻找理想的非动物蛋白。第一款Alver Golden Chlorella产品于2017年5月在瑞士举行的欧洲保健食品展(Vitafoods Europe)上推出。
Byskov-Bridges表示,“我们已经确定了以下几种典型的目标客户:纯素食者、素食者以及半荤半素者。研究表明,72%的顾客是出于环保原因购买Alver Golden Chlorella的,有30%的人是因为运动和健康,还有10%的消费者则是因为不耐和过敏而选择购买该产品。我们正在努力扩增产品种类,创造出一系列富含蛋白质的产品。”
▎2、高蛋白冰淇淋Koupe
这家荷兰公司Koupe开发了一系列新型高蛋白冰激淋,并宣称其与普通冰激淋相比更加健康美味。该产品的热量降低了40%,糖分减少了70%,而蛋白质和膳食纤维含量却增加了3倍。该系列一部分产品的蛋白含量超过了三个蛋清,糖含量却低于一个苹果,而膳食纤维的含量也要高于部分西兰花。

一项独立研究表明,96%的荷兰人认为该冰淇淋非常美味。由于其健康益处,Koupe与荷兰的医院建立了一项名为“健康食疗(Food for Care)”的合作,同时参与合作的还有拉德堡德大学医学院以及位于阿姆斯特丹的AMC医院,在这些地方,Koupe被看作是更健康饮食的一个组成部分。
Koupe的四种口味在以下的荷兰超市均有销售:Albert Heijn、Jumbo、Dirk以及Deka Markt。在国际市场中,在英国最大的网上超市Ocado、丹麦的部分超市以及比利时的Albert Heijn超市中都能够买到Koupe。
该公司的Jaco Pieper表示,“我们的蛋白冰淇淋面临的挑战是口感,如何能在减少糖和脂肪含量的同时,仍能为消费者带来一种能够提供奶油质感和饱腹感的美味爽滑产品呢?如何才能创造出一种可以纵情享受的不含有不健康配料的完美产品呢?我们通过在冰淇淋产品中加入乳清蛋白和膳食纤维来做到这一点,这些配料替代了脂肪和糖的一些功能。但蛋白质存在一些口味问题,所以我们选择合适的口味以达到真正的平衡,例如添加优质可可粉等。”
▎3、Nutrition Innovation:健康的低GI工业糖
Nutrition Innovation公司带来了Nucane,这是一款加工工艺简单且更健康的低GI工业糖,它可以直接作为一种糖替代品用在任何品牌的产品配方中。作为NutritionInnovation的首席科学官和创始人,David Kannar博士有一个愿景,那就是创造一种任何产品配方都可轻松使用的工艺简单且更健康、更低GI的工业糖。

Nucane的生产过程涉及到在现有的食品级糖生产工厂中安装近红外技术。一旦安装完毕,通过一种专有的算法,就可以不间断地精确生产特定规格的Nucane。 该产品的上市意味着各大品牌可以从一家原始生产工厂直接买到更健康的低GI工业糖,从而可以不再依赖于现有的大量精致的加工糖。
该公司的CEO Matthew Godfrey指出,食品和饮料行业想要更健康的选择,但价格必须要经济实惠,能够与他们的全球基础设施和规模上协调一致,同时要与现有的口味和配方相匹配。但他们也致力于实现联合国的可持续发展目标,所以需要尽快对整个供应链做出调整。制糖厂在基础设施方面需要大笔的资金投入,因此任何创新都要在符合质量和食品安全标准的同时保证高效、环保。
此外,它还需要满足客户的需求。消费者想要更健康的选择,但却不得不在口味和价格上做出妥协。任何想要在全球范围内取得大规模成功的快速改变都需要与现有的消费者偏好相符合,绝不能背道而驰。政府希望减少日益增长的医疗问题以及用于治疗肥胖症和糖尿病的成本,并希望消费者做出更健康的选择,但他们需要的是简单的选择以及对已在该生态系统中的品牌和企业的支持。我们的创新有助于克服这些挑战。这就是我们称它为 Nucane的原因之一,这是一款优质糖,对生态系统的不同群体都是有益无害的。
在大多数品牌的配方中,Nucane可以作为现有用糖的1:1替代品,因为它是100%蔗糖,可适用于零售行业的工业客户,如烘焙食品、饮料、乳制品、豆奶、糖果、巧克力、冰淇淋、调味酱和谷类食品等各种需要添加糖的产品。今年9月,该公司与他们的合作伙伴在澳大利亚的曼尼德拉进行了第一次设备安装和生产。Godfrey介绍说:“我们是该地区领先的生产集团之一,也是世界上第一个生产优质糖的企业。”

他补充说:“我们与领先的食品工程公司—Foss和施耐德合作,这样我们就可以迅速扩充到世界上任何一家接受该技术的工厂,并将其打造成生产食品级用糖的工厂。我们重点开拓的关键市场将是泰国、巴西、墨西哥、印度和非洲。对于工业客户来说,这些产品存在于世界上的每一个市场,我们目前正在与亚洲、欧洲和澳大利亚的客户进行样品协议。”
▎4、Innovopro鹰嘴豆蛋白
该公司开发了一种独特的创新技术,可以从鹰嘴豆中提取蛋白质含量高达70%的浓缩物。该产品声称满足了食品工业对可持续、可信赖的营养和高功能植物蛋白的需求,从而满足了对豆类蛋白不断增长的需求,同时也使得大豆蛋白的利用范围更加广泛。独特的营养和功效赋予了鹰嘴豆在植物蛋白市场中的独特价值。
鹰嘴豆被认为是一种具有多种健康益处的超级食物。鹰嘴豆蛋白可满足高品质植物蛋白不含添加剂的清洁标签产品配方需求,同时不会影响产品的口感或外观,是大豆、乳清蛋白、鸡蛋、谷蛋白和其他的绝佳替代品。

与许多其他植物蛋白不同,鹰嘴豆蛋白质还可作为乳化剂和发泡剂,为无乳制品、无谷蛋白和无蛋的产品带来多孔轻量的质构。鹰嘴豆蛋白的颜色很浅,风味精妙,是食品行业内多种应用的完美原料。它还允许在无添加剂添加的情况下通过创新的天然生产过程改善产品的质构。
▎5、Duplaco:生物异养微藻
这家私营公司在2016年开始以可持续的生物异养的方式生产生产微藻。其独特性在于较好的风味和营养健康的成分组成,因此可以作为人类食物和动物饲料中的一种配料。该产品据称是荷兰生产的第一款美味健康的小球藻。Duplaco开发了一种名为“异养培养”的创新发酵过程,可以生产高质量和美味的食品级(微)藻类。

通过这种可持续的、完全可控的无菌培养过程,他们可以一年365天不间断地产出新鲜的、液体小球藻。这种藻类含有很高的蛋白质含量(<45%),并且含有所有的必需氨基酸。此外,它还含有20%的健康膳食纤维、多种维生素和矿物质(如富含维生素D和铁)以及抗氧化物质。
来自Duplaco的Esther Heinen表示:“我们的微藻质量是如此之高,因此可以以高纯度(10%)的形式进行利用,而其他培养方法的纯度最高不超过0.3%。因此在得到同样数量的干重(粉末形式)时,我们需要使用的能量更少。”
她还说明了公司是如何通过自己的创新来生产这些高品质微藻的,那就是异养培养。“这意味着我们的微藻可以在没有阳光的条件下生长,这使我们能够在生物反应器内生产出完全无菌的微藻。利用这种方法,我们可以控制和调整其生长过程,从而实现对微藻的营养价值的干预。”
例如,该公司开发了一种富含蛋白质(45%)、铁和维生素D的微藻。另一方面的创新在于其风味与其他培养方法生产的产品完全不同。她说:“其味道温和适中,可以在食品中大量使用,而不会产生负面的味觉影响。”
Heinen解释说,该公司可以提供新鲜的(不同浓度的液体)和粉末形式的微藻。除此之外,他们还可以控制(新鲜)微藻的营养价值和结构。在商业应用方面,她指出,已用在了食品和饲料市场许多成品中。
她介绍说:“我们的一位顾客用我们新鲜的绿藻做了一份纯素的‘海藻牛排’。另一位客户则从我们的藻类中获得了健康的灵感。我们的大多数新客户都在从事新鲜食品行业,这也是我们认为的微藻最好的应用领域。在饲料市场中,它被用来提高动物的健康水平。例如,动物的免疫系统会得到增强,这样农民就可以少用抗生素了。它还被用作宠物饲料和鱼类食物。”
▎6、Flying Spark苍蝇蛋白
到2040年,全球人口将达到90多亿。蛋白质是日常饮食的重要组成部分。由于目前人们对蛋白质的兴趣增加,对蛋白质供应是否充足也保持着长期关注,可以预测在不久的将来动物蛋白将会严重短缺,寻找可供人类消费的环保型蛋白质来源变得至关重要。

Flying Spark公司找到了将苍蝇蛋白加入到人类食品中的新方法,并且已经可以用于工业化生产。该技术将饲养和加工苍蝇结合起来;它是一个非常高效的生物工厂,将多余水果转化为高质量蛋白粉,对环境影响极小。
▎7、GMR:生物量
这家高度创新的公司已经开发多种新方法来获取和利用所有涉及到提取领域的生物物质。GMR的目标是通过副产品利用的方法建立最高效的生物物质链。他们利用最先进的改造技术,为全世界提供新一代的生物物质。GMR提供定制原料服务,供应奢华独家的生物物质作为观赏花卉,同时还会提供大量更为常见的品种。整个GMR网现在包含了超过10万吨的即用生物物质,提高了客户的CSR(企业社会责任)和竞争力,也提高了供应商的收入。

GMR董事长兼创始人Julien Lesage指出:“该产品主要基于应用创新,而非技术创新。我们建立了一个网络模型,可以为生产链每一个环节(从种植到销售)所产生的植物副产品提供价值。通过这种方式,我们为提取市场提供了一个更智能、更具竞争力的来源。同时,我们也获得了一些工艺过程的专用权,让我们成为各种生物量的唯一供应商。我们用来生产桃花的细化过程就是这种情况。”
在可能的应用领域方面,最典型的就是使用提取自果汁残渣的植物基原料进行生产的食品饮料公司。Lesage解释说:“当果实被挤压时,果汁就会流出,这是产品。此外,还会得到果渣,里面有果皮和种子。这些果皮可以用来提取天然提取物、天然色素和天然防腐剂等等。此外,在成熟的生产链中,果汁制造商可以使用自己的副产品提取物来扩大产品范围。”
使用该技术生产的产品已经问世了,既有提取物产品也有终成品。目前,化妆品领域的需求最大,因为这也是该公司的首要目标市场。Lesage总结道:“很快我们的第一款食品饮料提取物即将问世。我们的合作伙伴包括世界顶尖的食品饮料集团、世界顶尖的提取物生产商以及几乎所有化妆品行业的巨头。”
▎8、Mazza Innovation加压水萃取工艺
乙醇、甲醇、丙酮和乙酸乙酯等化学萃取剂常用来从植物中提取有价值的成分以用于食品、饮料、膳食补充剂和个人护理产品。但不幸的是,在使用这些化学物质的过程中,必定随之产生环境污染和废液处理问题,再加上工人和消费者的安全问题,这就成了一个棘手的课题。
Mazza Innovation开发了一种名为PhytoClean Method的加压水萃取法,这种方法避免提取过程中化学溶剂的使用。只需要通过改变压力和热量来降低水的极性,使水像化学溶剂一样发挥作用,从而生产出无溶剂且标签清洁的植物提取物,同时还能够消除处理危险化学溶剂所涉及的安全和成本问题。这一突破声称能够避免最终配料中任何溶剂残留物的污染,并终结对污染废物安全环境的处置。

在2017年9月,Mazza宣布,已经从现有的和新股东中筹集了300万加元(合2.36万美元),以用于其在三角洲地区增设新的PhytoClean设施。Mazza的融资来自于几家机构和个人投资者,其中包括Natural Products Canada (NPC),一家致力于将天然产品商业化的非盈利公司。
▎9、Algobiotech 天然蓝色素提取技术
随着消费者的健康意识越来越强,食品中天然配料的需求也随之增大。到目前为止,Phycocyanin(藻蓝蛋白)是目前欧洲市场上唯一被准予使用的天然食用蓝色色素。此种蓝色色素的提取过程十分复杂,一些成品相较于同类合成物而言,稳定性较差、价格也更昂贵。在这种情况下,Algobiotech开发出了从微藻中提取蓝色色素的专利方法,并正在扩大这一技术在食品工业中的应用。
Algobiotech藻类蛋白制备工艺的两个关键不同点是:一、只使用天然溶剂提取,可以安全食用,不会引起过敏反应;二、提取得到的藻胆蛋白具有高稳定性,这使其能够在环境温度下储存,与其他需要冷藏和避光保护的植物蛋白相比,更适合运输和较长的食品货架期。稳定性还保证了藻胆蛋白中天然含有的抗氧化物质的活性。

▎10、Chromologics天然生物色素
过去十年间,消费者对天然食品色素的需求有所增加。为了满足消费者和食品行业的严苛要求,我们需要新的替代品。目前使用的天然色素大多是通过化学手段从甜菜根、胡萝卜或昆虫等食品原料中提取的,这些色素在稳定性和可用性方面有其局限性,生产高度依赖季节,因此导致价格波动剧烈。现有的天然色素大多是从人类食用的食物中提取出来的。
Chromologics是一家生物科技公司,从事多年研究工作后,从丹麦技术大学独立出来。该公司研发了一种专利授权的的发酵过程,使用一种非转基因丝状真菌来生产生物色素。他们的主要产品是一种名为ChromoRed的红色素,对pH和热具有比同类红色素竞争产品更高的稳定性。
Chromologics公司的Anders Ødum介绍说:“我们产品具有双重特色:首先,它是一种天然非转基因低成本红色素,具有与市场现有产品相当甚至更高的技术稳定性。这意味着ChromoRed应用领域非常广泛,而现有色素只适用于少部分食物。第二,我们在浸没式生物反应器中利用真菌进行生产,与传统的从浆果和甜菜根等食物中提取色素相比,这种方法更可持续、更高效,获得的色素可以直接被用作食品而非原料。”
该公司的着色剂解决了胭脂红替代品这一行业挑战。胭脂红稳定性极佳,但由于它是从昆虫中提取的,不符合素食、洁食和清真食品标准,因此用户接受度较低。Anders Ødum补充说:“我们的生产平台能够快速、廉价地生产出高质量的产品,对环境影响极小。这种色素最适合固体食品,不过我们现在正努力进行改良使它可以应用于软饮料。”
最后,Ødum指出:“我们还处在开发阶段,需要获得注册审批和相应的E-number(欧盟食品添加剂代码)添加剂批准。这意味着,我们可能还需要3-4年才能进入市场。因此产品的潜在客户尚未正式确定。”
本文来源为Foodaily每日食品网,如转载请注明出处,违者必究。



评论